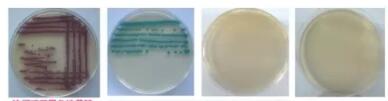
人纤维连接蛋白
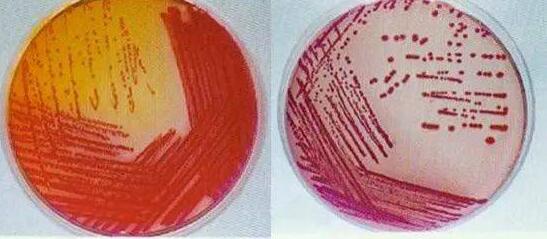
人纤维连接蛋白
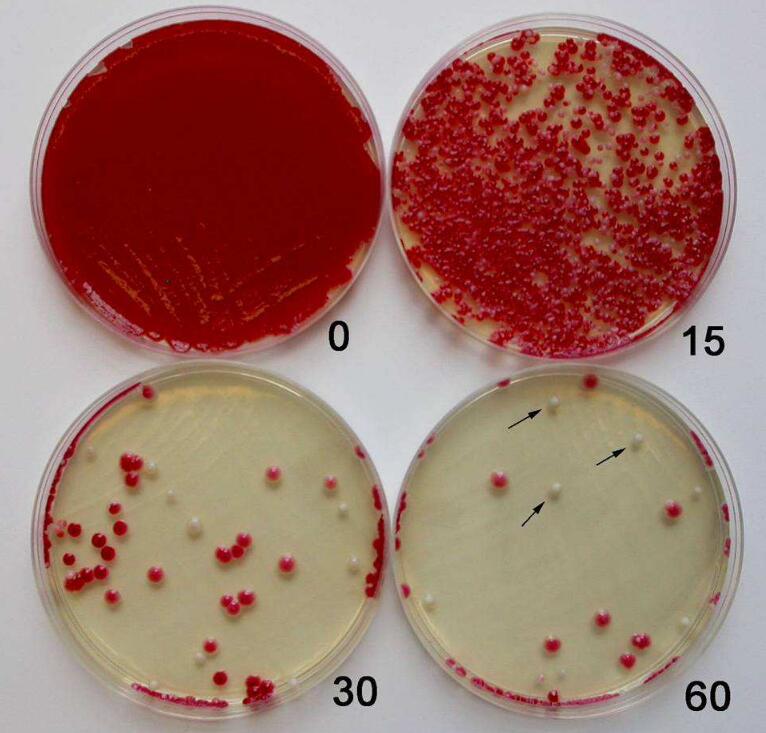
人纤维连接蛋白

相关产品推荐更多 >
万千商家帮你免费找货
0 人在求购买到急需产品
- 详细信息
- 技术资料
- 库存:
55
- 英文名:
Human Fibronectin
- 供应商:
上海西格
- 规格:
5mg

| 产品名称 | 人纤维连接蛋白 | 货号 | XG-PYJ8111 |
| 英文名称 | Human Fibronectin | 货期 | 现货 |
| 产品规格 | 5mg | 用途 | 仅供科研实验 |
细胞纤连蛋白(fibronectin,FN)是一种细胞外糖蛋白,分别以可溶形式存在于体液中,或以不可溶形式存在于细胞外基质中。作为主要的细胞粘附分子之一,FN在许多重要的生理过程中起着关键性作用,如胚胎生成,伤口愈合,止血和血栓形成。纤连蛋白表达的改变,降解以及组合与大量的病理发生密切相关,包括癌症和纤维化。
FN一般以二聚体形式分泌,各个单体的分子量为220~250kDa。主要由成纤维细胞、内皮细胞、软骨细胞、神经胶质细胞和肌细胞等合成,并分布在周围。器官移植会激发一系列的免疫级联反应,FN在T细胞活化
基本培养基和完全培养基的区别:

成分和用途
基本培养基和完全培养基的主要区别在于它们的成分和用途。基本培养基仅能满足微生物野生型菌株生长需要的最低成分,有时用符号“[ - ]”来表示,它又称无机盐培养基。完全培养基则是在基本培养基的基础上添加了一些富含氨基酸、维生素和碱基之类的天然物质,即加入生长因子而制成的各种营养基,可用来满足微生物的各种营养缺陷型菌株的生长需要。完全培养基有时用符号“[ + ]”表示,它在微生物学上常用,并且根据添加血清量的多少,可分为细胞生长培养基和细胞维持培养基,用于不同细胞和不同研究。
基本培养基;仅能满足微生物野生型菌株生长需要的培养基,成为基本培养基。完全培养基;凡可满足一切营养缺陷型菌株营养需要的天然或者半天然培养基,成为完全培养基。
补充培养基:凡是只能满足相应的营养缺陷型生长需要的组合培养基,称为补充培养基,是在基本培养基中加入该菌株不能合成的营养因子而组成的。
培养基的种类:

1.1 基本培养基和完全培养基
根据其组成,通常分为基本培养基和完全培养基。基本培养基仅含大量元素、微量元素、维生素、氨基酸、糖及水;而完全培养基是在基本培养基的基础上根据不同的培养要求,添加各种植物生长调节物质及附加物。
1.2 固体培养基和液体培养基
在配制培养基时,若加入适量的凝固剂(琼脂)则成为固定培养基;如果不加凝固剂,则为液体培养基。由于固体培养基使用简便,目前使用最为普遍。
1.3 基本培养基的种类及特点
基本培养基的种类非常多,但是较为常用的还是一二十种,如:MS、改良MS、White、改良White、B5、Nitsch、Blaydes、N6、H、VW、改良VW、MT、NT、SH、BL、ER、LS、WS等基本培养基
培养基常见问题:

(1) 培养基灭菌后,需要冷却到50 ℃左右时,才能用来倒平板,你用什么办法来估计培养基的温度?
答:一般是放到50 ℃左右的恒温水浴锅里,如果没有水浴锅,用手触摸盛有培养基的锥形瓶,感觉锥形瓶的温度下降到刚刚不烫手时,就可以进行倒平板了。
(2) 为什么在用“分划线分离法”接种时,每次要灼烧接种环
答:防止杂菌,提高培养纯度。
(3) 请问生物的平板划线分离法划线时都有那些技巧啊~~~
答:平板划线分离法要求后面的划线要在前一次的末尾划线,在作时要细心,划线的手尽量维持前面的姿势,左手转动培养皿。
(4) 用平板划线分离法分离土壤渗出液中的细菌后,分离出来的纯种菌?
答:只能说放线菌是比较多的,因为土壤这个环境适合它的生长!你说能否分离其他菌?也可以吧!在进行划线之后平板会出现多菌,像放线菌,细菌,真菌等;接下来就是鉴定了,再之后就是纯化了,这样应该可以分离所需菌种!
公司正在出售的产品:

HA重组甲型流感 H5N3 (A/duck/Hokkaido/167/2007) 血凝素HA1 (Hemagglutinin) 蛋白 (His 标签) Protein 酸性L-G培养基基础 Acid L-G medium Base 250 适用于碱性物质处理的结核杆菌标本
载脂蛋白A1(APOA1)重组蛋白 Recombinant Apolipoprotein A1 (APOA1) DRBC培养基250g/瓶用于食品中霉菌及酵母菌的分离培养和计数incubationmediaDRBC培养基250g/瓶用于食品中霉菌及酵母菌的分离培养和计数
PMSF(10mM) 10ml 2216E琼脂 250g 用于海生细菌的培养和计数
IFNGR1 Protein Human IFNGR1 / CD119 蛋白 (His 标签) WILKINS-CHALGREN琼脂250g用于厌氧菌的分离培养
EFNA1 Ephrin-A1 / EFNA1 蛋白 (His & Fc 标签) Protein MEI培养基 MEI Medium 用于一步滤膜法显色检测或计数水中的肠球菌
HA重组甲型流感 H5N1 (A/Egypt/2321-NAMRU3/2007) 血凝素 (Hemagglutinin / HA) 蛋白 (His 标签) Protein 支原体培养基基础 Mycoplasma Broth Base 250 用于培养支原体的基础培养基
载脂蛋白H(APOH)重组蛋白 Recombinant Apolipoprotein H (APOH) 葡萄糖蛋白胨肉汤250g/瓶用于霉菌、酵母菌检测(日本药典)incubationmedia葡萄糖蛋白胨肉汤250g/瓶用于霉菌、酵母菌检测(日本药典)
PMSF(晶体) 1g 大肠菌群、粪大肠菌群、大肠杆菌检验培养基
INSR Protein Human Insulin Receptor / INSR / CD220 蛋白 (short isoform, His 标签) 大豆酪蛋白消化物琼脂培养基250g用于药品中需氧菌总数测定
VEGFA / 食蟹猴 VEGF / VEGFA / VEGF165 蛋白 Protein mEI琼脂(肠球菌显色培养基) 1000mL/瓶 incubation media mEI琼脂(肠球菌显色培养基) 1000mL/瓶
人纤维连接蛋白HA重组甲型流感 H5N1 (A/Egypt/2321-NAMRU3/2007) 血凝素HA1 (Hemagglutinin) 蛋白 (His 标签) Protein 哥伦比亚琼脂培养基 250g 用于营养要求较高的细菌的培养及溶血试验,还用于药品中梭菌的检测。(《中华人民共和国药典》201...
风险提示:丁香通仅作为第三方平台,为商家信息发布提供平台空间。用户咨询产品时请注意保护个人信息及财产安全,合理判断,谨慎选购商品,商家和用户对交易行为负责。对于医疗器械类产品,请先查证核实企业经营资质和医疗器械产品注册证情况。
 技术资料
技术资料暂无技术资料 索取技术资料
人纤维连接蛋白
¥680 - 3600









